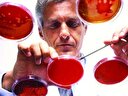

Sağlık Bakanı Fahrettin Koca, sosyal medya hesabı üzerinden bir paylaşımda bulundu. Bakan Koca, evlilik öncesi SMA taraması uygulamasından 2 yılda 1 milyon 834 kişinin yararlandığını açıkladı. Koca, Tarama programının 27 Aralık 2021'den itibaren 81 ilde uygulandığını belirtti.
Sağlık Bakanı Fahrettin Koca, sosyal medya hesabından yaptığı açıklamada, SMA hastalığının önlenmesine yönelik, evlenecek çiftlerin taşıyıcılık testinden geçmesini amaçlayan tarama programının 27 Aralık 2021'den itibaren 81 ilde uygulandığını belirtti.

SMA hastalığının önlenmesine yönelik, evlilik öncesinde çiftlerin taşıyıcılık testinden geçmesini amaçlayan tarama programımız, 27 Aralık 2021 tarihinden itibaren, 81 ilde uygulanıyor. Programın uygulamaya konulmasından 4 Eylül 2023’e kadar 1 Milyon 834 kişi tarandı.
Alınan numunelerin analizi sonucunda, ‘’SMA Taşıyıcılığı Şüpheli’’ olarak tespit edilen 22 Bin 573 kişi için elde edilen veriler, programın SMA hastalığının yayılmasını engelleme ve erken teşhis konusundaki önemini göstermiştir.
SMA, toplumda her 50 kişiden birinde görülebilen genetik bir hastalık. Ebeveynlerin her ikisi de taşıyıcı olduğunda bebekte hastalık riski %25'e kadar yükselmektedir. Bu nedenle, SMA taşıyıcılığını evlilik öncesinde saptamak, potansiyel riski azaltma açısından büyük bir önem taşıyor.
SMA tarama testleri, evlilik öncesi dönemde, Sağlık Bakanlığı tarafından ücretsiz yapılmakta ve aile hekimliklerince yürütülmektedir. Ayrıca, gebelik döneminde de, talep eden çiftlere tarama testi uygulanıyor.
Tarama sonuçları 2 hafta içinde elde edilmekte ve e-Nabız uygulaması aracılığıyla kolayca sonuçlara erişilebilmektedir.
Ayrıca, programın bir parçası olarak, çiftlerin taşıyıcı olduğu belirlendiğinde, sağlıklı bir çocuk sahibi olabilmeleri için genetik danışma hizmeti sunuluyor. Bu danışma, doğum öncesi veya tüp bebek aşılama öncesi tanı testi gibi seçenekleri içermektedir.
Şayet çiftlerden sadece birinin taşıyıcılığı şüpheli ise, diğerinin de sessiz taşıyıcı olma ihtimaline karşı, Tıbbi Genetik Uzmanına yönlendirilerek, daha detaylı bir inceleme yapılması ve danışmanlık imkânına kavuşması bedelsiz olarak sağlanmaktadır.
SMA, ilerleyici bir motor nöron hastalığıdır, tedavi edilmediğinde ciddi sağlık sorunlarına yol açar. Bu nedenle, evlilik öncesi SMA Tarama Programı erken teşhis ve önleme açısından kritik bir rol oynamaktadır.